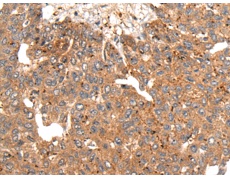
一抗

中文名稱:兔抗CGAS多克隆抗體
英文名稱: Anti-CGAS rabbit polyclonal antibody
別 名: cyclic GMP-AMP synthase; MB21D1; h-cGAS; C6orf150
相關類別: 一抗
儲 存: 冷凍(-20℃)
抗 原: CGAS
宿 主: Rabbit
反應種屬: Human
標 記 物: Unconjugate
克隆類型: rabbit polyclonal
技術規(guī)格
|
Background: |
cGAS (cyclic GMP-AMP synthase), also known as MB21D1 (Mab-21 domain containing 1), h-cGAS or C6orf150, is a 522 amino acid cytoplasmic nucleotidyltransferase that catalyzes the formation of cyclic GMP-AMP (cGAMP) from ATP and GTP. cGAS is suggested to have antiviral activity by acting as a key cytosolic DNA sensor. cGAS binds to cytosolic DNA, which leads to cGAMP synthesis and activation of TMEM173, thereby trigger type-I interferon production. Expressed in monocytic cell line THP1, cGAS exists as two alternatively spliced isoforms and is encoded by a gene located on human chromosome 6q13. |
|
Applications: |
ELISA, WB, IHC |
|
Name of antibody: |
CGAS |
|
Immunogen: |
Synthetic peptide of human CGAS |
|
Full name: |
cyclic GMP-AMP synthase |
|
Synonyms: |
MB21D1; h-cGAS; C6orf150 |
|
SwissProt: |
Q8N884 |
|
ELISA Recommended dilution: |
5000-10000 |
|
IHC positive control: |
Human liver cancer |
|
IHC Recommend dilution: |
20-100 |
|
WB Predicted band size: |
59 kDa |
|
WB Positive control: |
HT-29 and Lovo cell lysates |
|
WB Recommended dilution: |
500-2000 |


 購物車
購物車 幫助
幫助
 021-54845833/15800441009
021-54845833/15800441009